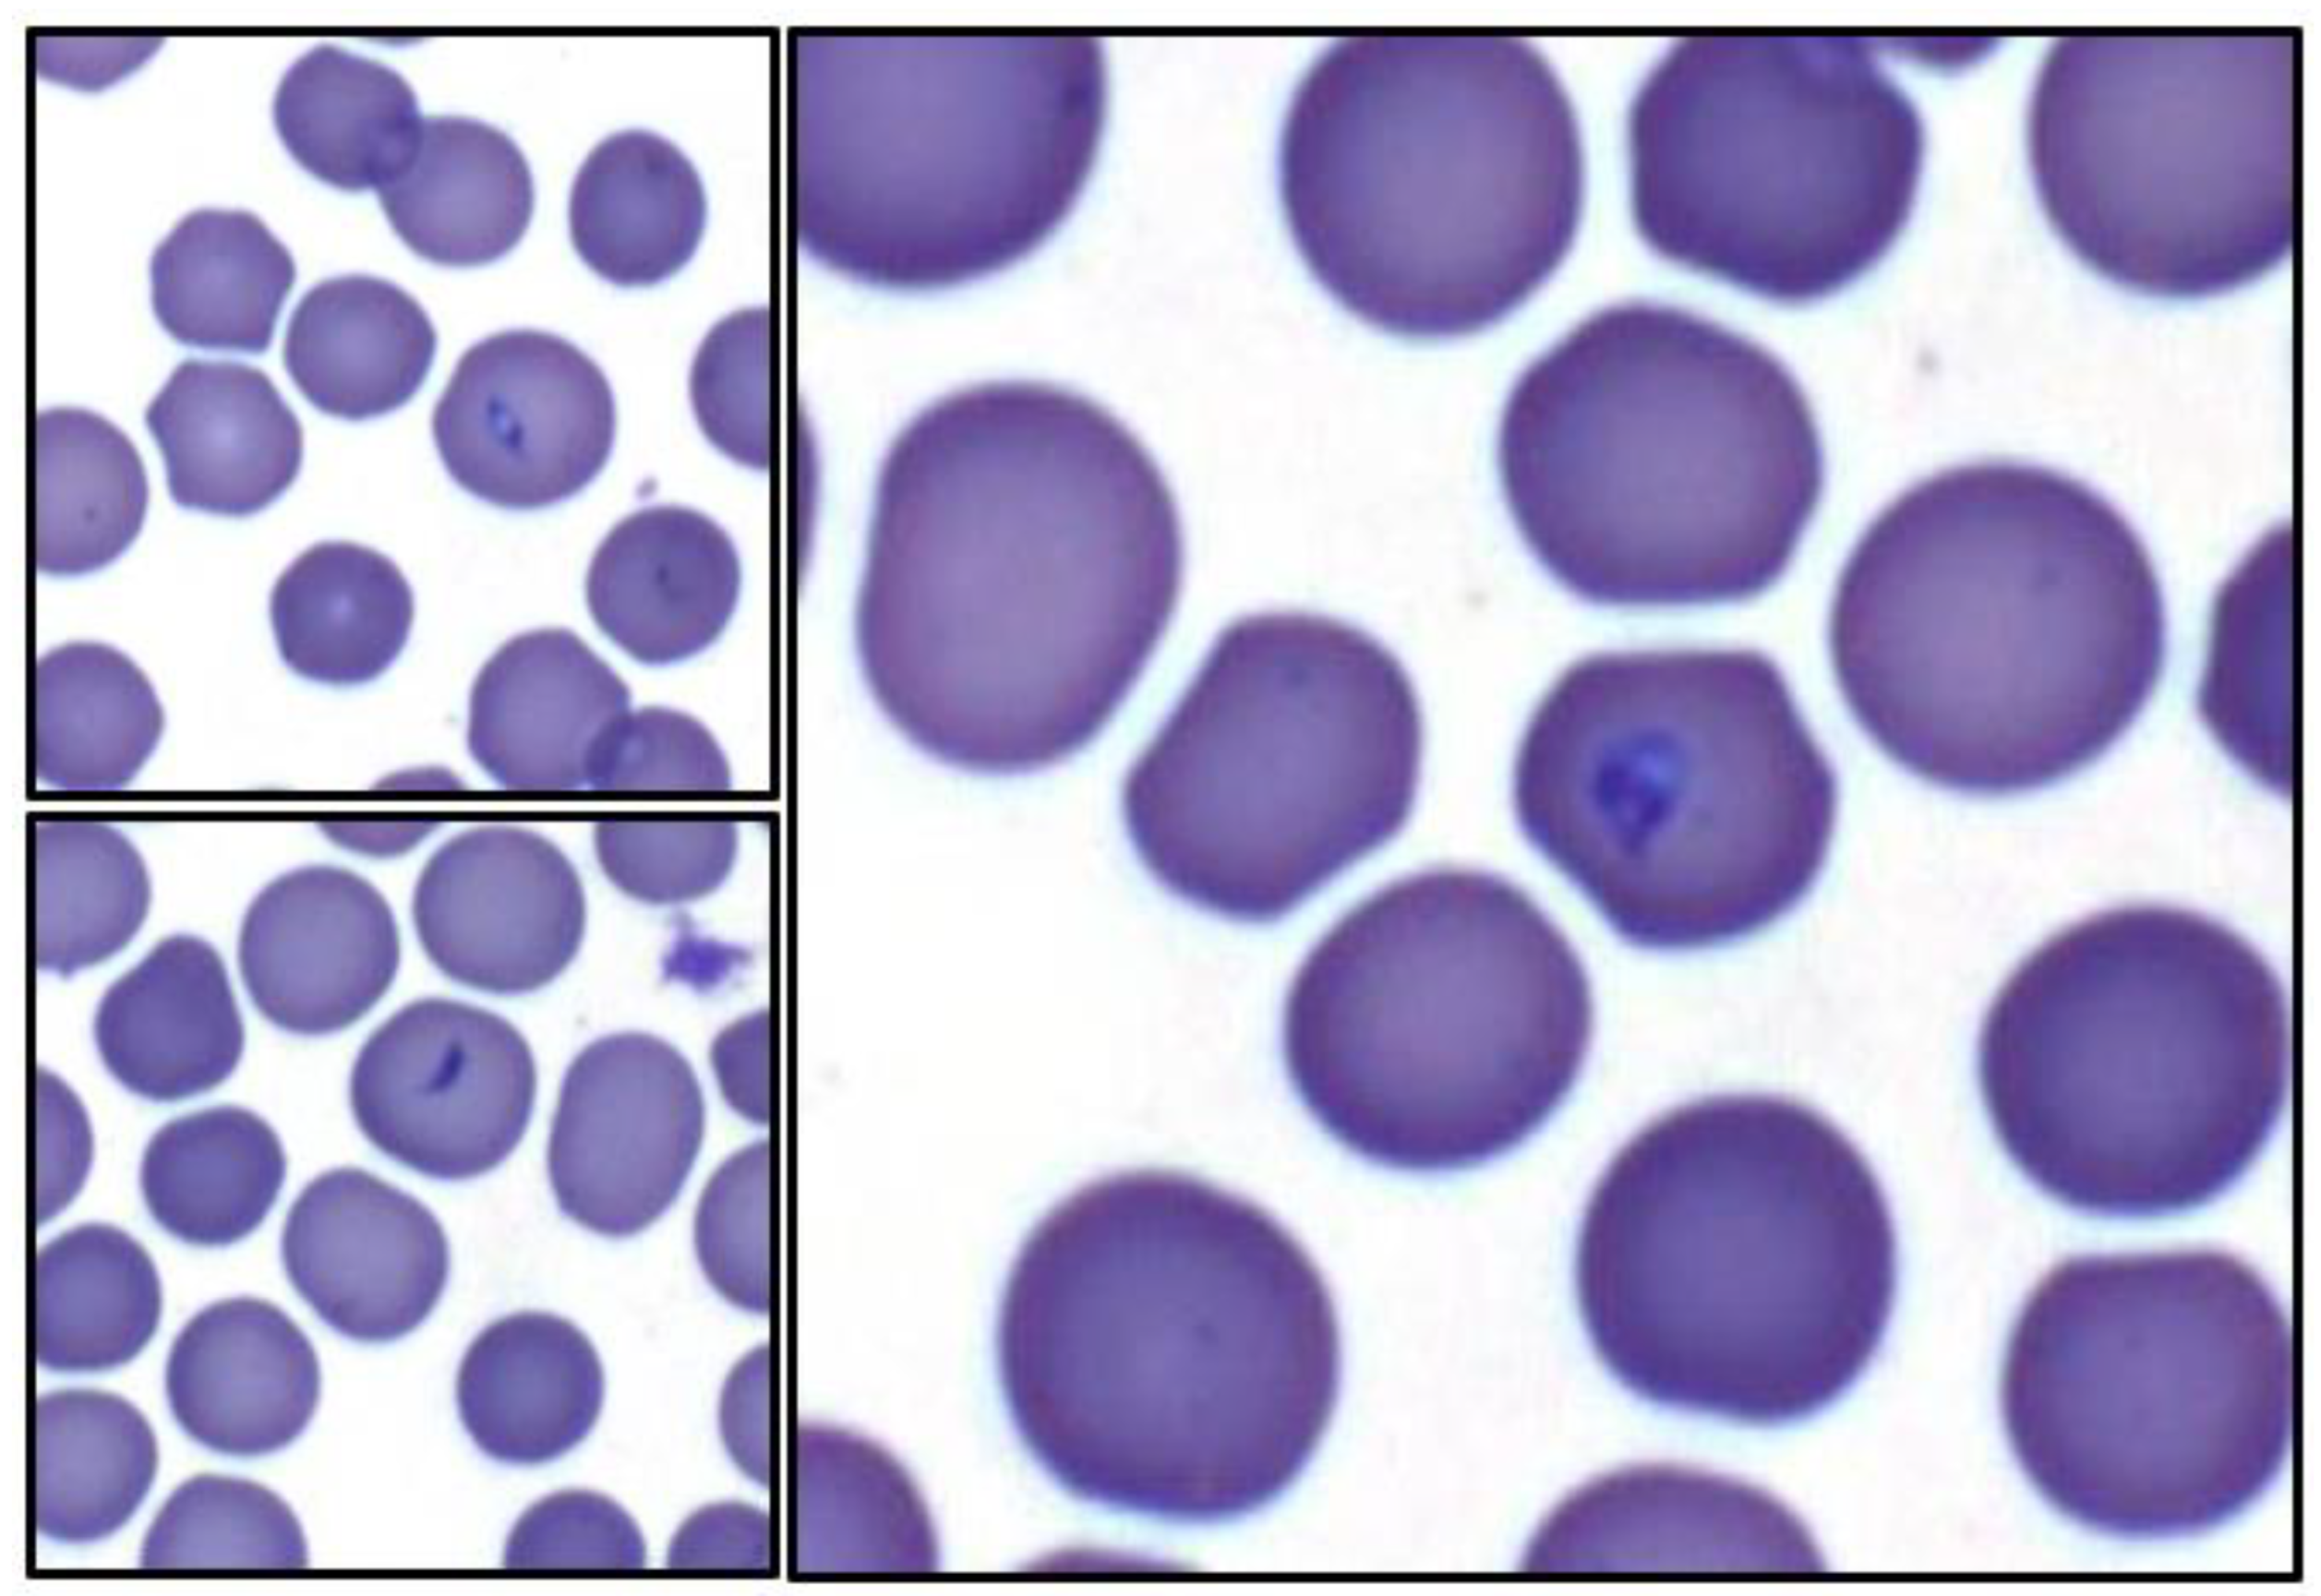

Tulathromycin and Diclazuril Lack Efficacy against Theileria haneyi, but Tulathromycin Is Not Associated with Adverse Clinical Effects in Six Treated Adult Horses
Abstract
1. Introduction
2. Materials and Methods
2.1. Horses
2.2. Post-Infection Monitoring and Assessment of Parasitemia
2.3. T. haneyi Nested PCR
2.4. Tulathromycin Treatment
2.5. Diclazuril Treatment
2.6. Necropsy and Histopathology
3. Results
3.1. Theileria haneyi Infection Outcome
3.2. Tulathromycin Treatment Outcome
3.3. Tulathromycin Safety
3.4. Diclazuril Treatment Outcome
4. Discussion
Supplementary Materials
Author Contributions
Funding
Institutional Review Board Statement
Informed Consent Statement
Data Availability Statement
Acknowledgments
Conflicts of Interest
References
- Knowles, D.P.; Kappmeyer, L.S.; Haney, D.; Herndon, D.R.; Fry, L.M.; Munro, J.B.; Sears, K.; Ueti, M.W.; Wise, L.N.; Silva, M.; et al. Discovery of a novel species, Theileria haneyi n. sp., infective to equids, highlights exceptional genomic diversity within the genus Theileria: Implications for apicomplexan parasite surveillance. Int. J. Parasitol. 2018, 48, 679–690. [Google Scholar] [CrossRef] [PubMed]
- Wise, L.N.; Kappmeyer, L.S.; Mealey, R.H.; Knowles, D.P. Review of equine piroplasmosis. J. Vet. Intern. Med. 2013, 27, 1334–1346. [Google Scholar] [CrossRef] [PubMed]
- Wise, L.N.; Pelzel-McCluskey, A.M.; Mealey, R.H.; Knowles, D.P. Equine piroplasmosis. Vet. Clin. Equine Pract. 2014, 30, 677–693. [Google Scholar] [CrossRef]
- Bishop, R.P.; Kappmeyer, L.; Onzere, C.K.; Odongo, D.; Githaka, N.; Sears, K.P.; Knowles, D.P.; Fry, L.M. Equid infective Theileria cluster in distinct 18S rRNA gene clades comprising multiple taxa with unusually broad mammalian host ranges. Parasites Vectors 2020, 13, 261. [Google Scholar] [CrossRef] [PubMed]
- O’Connor, R.M.; Nepveux, V.F.J.; Abenoja, J.; Bowden, G.; Reis, P.; Beaushaw, J.; Bone Relat, R.M.; Driskell, I.; Gimenez, F.; Riggs, M.W.; et al. A symbiotic bacterium of shipworms produces a compound with broad spectrum anti-apicomplexan activity. PLoS Pathog. 2020, 16, e1008600. [Google Scholar] [CrossRef]
- Singh, B.; Banerjee, D.P.; Gautam, O.P.; Gupta, R.K.P. Clinicopathological changes in splenectomised donkeys infected with Babesia equi. Indian J. Parasitol. 1980, 4, 77–80. [Google Scholar]
- Guimarães, A.; Lima, J.; Tafuri, W.; Ribeiro, M.; Sciavicco, C.; Botelho, A. Clinical and histopathological aspects of splenectomized foals infected by babesia equi. J. Equine Vet. Sci. 1997, 17, 211–216. [Google Scholar] [CrossRef]
- Kuttler, K.L.; Gipson, C.A.; Goff, W.L.; Johnson, L.W. Experimental Babesia equi infection in mature horses. Am. J. Vet. Res. 1986, 47, 1668–1670. [Google Scholar]
- Sears, K.P.; Kappmeyer, L.; Wise, L.N.; Silva, M.; Ueti, M.W.; White, S.; Reif, K.E.; Knowles, D.P. Infection dynamics of Theileria equi and Theileria haneyi, a newly discovered apicomplexan of the horse. Vet. Parasitol. 2019, 271, 68–75. [Google Scholar] [CrossRef]
- Sears, K.P.; Knowles, D.P.; Fry, L.M. Clinical Progression of Theileria haneyi in Splenectomized Horses Reveals Decreased Virulence Compared to Theileria equi. Pathogens 2022, 11, 254. [Google Scholar] [CrossRef]
- Sears, K.; Knowles, D.; Dinkel, K.; Mshelia, P.; Onzere, C.; Silva, M.; Fry, L. Imidocarb Dipropionate Lacks Efficacy against Theileria haneyi and Fails to Consistently Clear Theileria equi in Horses Co-Infected with T. haneyi. Pathogens 2020, 9, 1035. [Google Scholar] [CrossRef] [PubMed]
- Grause, J.F.; Ueti, M.W.; Nelson, J.T.; Knowles, D.P.; Kappmeyer, L.; Bunn, T.O. Efficacy of imidocarb dipropionate in eliminating Theileria equi from experimentally infected horses. Vet. J. 2013, 196, 541–546. [Google Scholar] [CrossRef] [PubMed]
- Kuttler, K.L.; Zaugg, J.L.; Gipson, C.A. Imidocarb and parvaquone in the treatment of piroplasmosis (Babesia equi) in equids. Am. J. Vet. Res. 1987, 48, 1613–1616. [Google Scholar]
- Ueti, M.W.; Mealey, R.H.; Kappmeyer, L.S.; White, S.N.; Kumpula-McWhirter, N.; Pelzel, A.M.; Grause, J.F.; Bunn, T.O.; Schwartz, A.; Traub-Dargatz, J.L.; et al. Re-emergence of the apicomplexan Theileria equi in the United States: Elimination of persistent infection and transmission risk. PLoS ONE 2012, 7, e44713. [Google Scholar] [CrossRef] [PubMed]
- Leclere, M.; Magdesian, K.G.; Cole, C.A.; Szabo, N.J.; Ruby, R.E.; Rhodes, D.M.; Edman, J.; Vale, A.; Wilson, W.D.; Tell, L.A. Pharmacokinetics and preliminary safety evaluation of azithromycin in adult horses. J. Vet. Pharmacol. Ther. 2011, 35, 541–549. [Google Scholar] [CrossRef]
- Villarino, N.; Brown, S.A.; Martín-Jiménez, T. The role of the macrolide tulathromycin in veterinary medicine. Vet. J. 2013, 198, 352–357. [Google Scholar] [CrossRef]
- Villarino, N.; Denny, J.E.; Schmidt, N.W. Antimalarial Activity of Tulathromycin in a Murine Model of Malaria. Antimicrob. Agents Chemother. 2015, 59, 3672–3674. [Google Scholar] [CrossRef]
- Silva, M.G.; Villarino, N.F.; Knowles, D.P.; Suarez, C.E. Assessment of Draxxin((R)) (tulathromycin) as an inhibitor of in vitro growth of Babesia bovis, Babesia bigemina and Theileria equi. Int. J. Parasitol. Drugs Drug Resist. 2018, 8, 265–270. [Google Scholar] [CrossRef]
- Rutenberg, D.; Venner, M.; Giguère, S. Efficacy of Tulathromycin for the Treatment of Foals with Mild to Moderate Bronchopneumonia. J. Vet. Intern. Med. 2017, 31, 901–906. [Google Scholar] [CrossRef]
- Mercer, M.A. Macrolide Use in Animals. Merck Veterinary Manual 2022. 2023. Available online: https://www.merckvetmanual.com/pharmacology/antibacterial-agents/macrolide-use-in-animals (accessed on 7 February 2023).
- Båverud, V.; Franklin, A.; Gunnarsson, A.; Gustafsson, A.; Hellander-Edman, A. Clostridium difficile associated with acute colitis in mares when their foals are treated with erythromycin and rifampicin for Rhodococcus equi pneumonia. Equine Vet. J. 1998, 30, 482–488. [Google Scholar] [CrossRef]
- Gustafsson, A.; Bäverud, V.; Gunnarsson, A.; Rantzien, M.H.; Lindholm, A.; Franklin, A. The association of erythromycin ethylsuccinate with acute colitis in horses in Sweden. Equine Vet. J. 1997, 29, 314–318. [Google Scholar] [CrossRef] [PubMed]
- Leventhal, H.R.; McKenzie, H.C.; Estell, K.; Council-Troche, M.; Davis, J.L. Pharmacokinetics and pulmonary distribution of Draxxin((R)) (tulathromycin) in healthy adult horses. J. Vet. Pharmacol. Ther. 2021, 44, 714–723. [Google Scholar] [CrossRef]
- Stock, M.L.; ElAzab, S.T.; Hsu, W.H. Review of triazine antiprotozoal drugs used in veterinary medicine. J. Vet. Pharmacol. Ther. 2017, 41, 184–194. [Google Scholar] [CrossRef] [PubMed]
- Dirikolu, L.; Karpiesiuk, W.; Lehner, A.F.; Hughes, C.; Woods, W.E.; Harkins, J.D.; Boyles, J.; Atkinson, A.; Granstrom, D.E.; Tobin, T. New therapeutic approaches for equine protozoal myeloencephalitis: Pharmacokinetics of diclazuril sodium salts in horses. Vet. Ther. Res. Appl. Vet. Med. 2006, 7, 52–63. [Google Scholar]
- Dirikolu, L. Diclazuril in the horse: Its identification and detection and preliminary pharmacokinetics. J. Vet. Pharmacol. Ther. 1999, 22, 374–379. [Google Scholar] [CrossRef] [PubMed]
- Hunyadi, L.; Papich, M.G.; Pusterla, N. Pharmacokinetics of a low dose and FDA-labeled dose of diclazuril administered orally as a pelleted topdressing in adult horses. J. Vet. Pharmacol. Ther. 2014, 38, 243–248. [Google Scholar] [CrossRef] [PubMed]
- Pusterla, N.; Packham, A.; Mackie, S.; Kass, P.H.; Hunyadi, L.; Conrad, P.A. Daily feeding of diclazuril top dress pellets in foals reduces seroconversion to Sarcocystis neurona. Vet. J. 2015, 206, 236–238. [Google Scholar] [CrossRef]
- Wise, L.N.; Ueti, M.W.; Kappmeyer, L.S.; Hines, M.T.; White, S.N.; Davis, W.; Knowles, D.P. In vitro activity of ponazuril against Theileria equi. Vet. Parasitol. 2012, 185, 282–285. [Google Scholar] [CrossRef]
- Gajadhar, A.A.; Marquardt, W.C.; Hall, R.; Gunderson, J.; Ariztia-Carmona, E.V.; Sogin, M.L. Ribosomal RNA sequences of Sarcocystis muris, Theileria annulata and Crypthecodinium cohnii reveal evolutionary relationships among apicomplexans, dinoflagellates, and ciliates. Mol. Biochem. Parasitol. 1991, 45, 147–154. [Google Scholar] [CrossRef]
- Hostetter, J.M.; Uzal, F.A. Gastrointestinal biopsy in the horse: Overview of collection, interpretation, and applications. J. Vet. Diagn. Investig. 2022, 34, 376–388. [Google Scholar] [CrossRef]
- Rocchigiani, G.; Ricci, E.; Navarro, M.A.; Samol, M.A.; Uzal, F.A. Leukocyte numbers and intestinal mucosal morphometrics in horses with no clinical intestinal disease. J. Vet. Diagn. Investig. 2022, 34, 389–395. [Google Scholar] [CrossRef] [PubMed]
- Chaffin, M.K.; Fuenteabla, I.C.; Schumacher, J.; Welch, R.D.; Edwards, J.F. Idiopathic muscular hypertrophy of the equine small intestine: 11 cases (1980–1991). Equine Vet. J. 1992, 24, 372–378. [Google Scholar] [CrossRef] [PubMed]
- De Solís, C.N.; Biscoe, E.W.; Lund, C.M.; Labbe, K.; Muñoz, J.; Farnsworth, K. Imaging diagnosis--muscular hypertrophy of the small intestine and pseudodiverticula in a horse. Vet. Radiol. Ultrasound 2015, 56, E13–E16. [Google Scholar] [CrossRef]
- Hostettler, I.; Müller, J.; Hemphill, A. In Vitro Screening of the Open-Source Medicines for Malaria Venture Malaria Box Reveals Novel Compounds with Profound Activities against Theileria annulata Schizonts. Antimicrob. Agents Chemother. 2016, 60, 3301–3308. [Google Scholar] [CrossRef] [PubMed]
- Nugraha, A.B.; Tuvshintulga, B.; Guswanto, A.; Tayebwa, D.S.; Rizk, M.A.; Gantuya, S.; Batiha, G.E.-S.; Beshbishy, A.M.; Sivakumar, T.; Yokoyama, N.; et al. Screening the Medicines for Malaria Venture Pathogen Box against piroplasm parasites. Int. J. Parasitol. Drugs Drug Resist. 2019, 10, 84–90. [Google Scholar] [CrossRef]
- Nyagwange, J.; Awino, E.; Tijhaar, E.; Svitek, N.; Pelle, R.; Nene, V. Leveraging the Medicines for Malaria Venture malaria and pathogen boxes to discover chemical inhibitors of East Coast fever. Int. J. Parasitol. Drugs Drug Resist. 2019, 9, 80–86. [Google Scholar] [CrossRef]
- Rizk, M.A.; Baghdadi, H.B.; El-Sayed, S.A.E.-S.; Eltaysh, R.; Igarashi, I. Repurposing of the Malaria Box for Babesia microti in mice identifies novel active scaffolds against piroplasmosis. Parasites Vectors 2022, 15, 329. [Google Scholar] [CrossRef]
- Rizk, M.A.; El-Sayed, S.A.E.-S.; El-Khodery, S.; Yokoyama, N.; Igarashi, I. Discovering the in vitro potent inhibitors against Babesia and Theileria parasites by repurposing the Malaria Box: A review. Vet. Parasitol. 2019, 274, 108895. [Google Scholar] [CrossRef]
- Rizk, M.A.; El-Sayed, S.A.E.-S.; Eltaysh, R.; Igarashi, I. MMV020275 and MMV020490, promising compounds from malaria box for the treatment of equine piroplasmosis. Ticks Tick-Borne Dis. 2022, 13, 101904. [Google Scholar] [CrossRef]
- Hines, S.A.; Ramsay, J.D.; Kappmeyer, L.S.; Lau, A.O.; Ojo, K.K.; Van Voorhis, W.C.; Knowles, D.P.; Mealey, R.H. Theileria equi isolates vary in susceptibility to imidocarb dipropionate but demonstrate uniform in vitro susceptibility to a bumped kinase inhibitor. Parasites Vectors 2015, 8, 33. [Google Scholar] [CrossRef]
- Bowden, G.D.; Reis, P.M.; Rogers, M.B.; Relat, R.M.B.; Brayton, K.A.; Wilson, S.K.; Di Genova, B.M.; Knoll, L.J.; Nepveux, V.F.J.; Tai, A.K.; et al. A conserved coccidian gene is involved in Toxoplasma sensitivity to the anti-apicomplexan compound, tartrolon E. Int. J. Parasitol. Drugs Drug Resist. 2020, 14, 1–7. [Google Scholar] [CrossRef] [PubMed]
- Gimenez, F.; Hines, S.A.; Evanoff, R.; Ojo, K.K.; Van Voorhis, W.C.; Maly, D.J.; Vidadala, R.S.; Mealey, R.H. In vitro growth inhibition of Theileria equi by bumped kinase inhibitors. Vet. Parasitol. 2018, 251, 90–94. [Google Scholar] [CrossRef] [PubMed]

| Horse | Sex | Age (years) | Breed | Treatment | Group | Stabilate |
|---|---|---|---|---|---|---|
| 424 | Gelding | 8 | QH X | Tulathromycin | 1 | Horse 344, 12.69% PPE |
| 425 | Mare | 5 | Morgan X | |||
| 426 | Gelding | 5 | QH X | |||
| 427 | Mare | 5 | QH X | |||
| 429 | Gelding | 8 | TB X | |||
| 431 | Gelding | 15 | QH X | |||
| 417 | Mare | 1 | WP X | Diclazuril Post-Infection | 2 | Horse 344, 6.1% PPE |
| 418 | Mare | 1 | WP X | |||
| 420 | Stallion | 1 | WP X | |||
| 124 | Mare | 16 | WP X | Diclazuril Pre/Post-Infection | 3 | |
| 173 | Mare | 11 | WP X | |||
| 419 | Mare | 1 | WP x | |||
| 411 | Mare | 2 | WP X | None | Control | |
| 413 | Mare | 2 | WP X |
| Horse | Group | Pre-Infection | Pre-Tx | Post-Tx 1 | Post-Tx 2 | Post-Tx 3 | Post-Tx 4 | Post-Tx 5 | Post-Tx 6 | Post-Tx 7 | Post-Tx 8 |
|---|---|---|---|---|---|---|---|---|---|---|---|
| 424 | 1 | - | + | + | + | + | + | + | + | + | + |
| 425 | 1 | - | + | + | + | + | + | + | + | + | + |
| 426 | 1 | - | + | + | + | + | + | + | + | + | + |
| 427 | 1 | - | + | + | + | + | + | + | + | + | + |
| 429 | 1 | - | + | + | + | + | + | + | + | + | + |
| 431 | 1 | - | + | + | + | + | + | + | + | + | + |
| Horse | Group | Diarrhea | Colic | Fever | Anorexia | Depression | Injection Site Pain |
|---|---|---|---|---|---|---|---|
| 424 | 1 | Mild, transient | Mild to moderate | - | - | - | - |
| 425 | 1 | - | - | - | - | - | - |
| 426 | 1 | - | - | - | - | - | - |
| 427 | 1 | - | Mild, transient | - | - | - | - |
| 429 | 1 | - | - | - | - | - | - |
| 431 | 1 | - | - | - | - | - | - |
| Horse | Group | Intercurrent Health Issues |
|---|---|---|
| 424 | 1 | None |
| 425 | 1 | Cutaneous foreign body, intermittent urticaria |
| 426 | 1 | Papillomas on muzzle |
| 427 | 1 | Skin mass on chest, transient cough, and nasal discharge |
| 429 | 1 | None |
| 431 | 1 | Intermittent urticaria, scar with granulation tissue/intermittent swelling on right rear leg, intermittent ventral edema (“stocking up”) |
| Horse | Skin | Brain and Pituitary Gland | Heart | Lungs, Trachea | GI Tract * | Liver | Kidneys | Spleen |
|---|---|---|---|---|---|---|---|---|
| 424 | NSF | Pituitary cyst | NSF | NSF | Muscular hypertrophy of ileum, few cyathostomes | Mild periportal infiltrate | NSF | NSF |
| 425 | NSF | NSF | NSF | NSF | NSF | Mild periportal infiltrate | Mild interstitial nephritis | NSF |
| 426 | Muzzle papilloma | NSF | NSF | NSF | Encysted cyathostomes | Mild periportal infiltrate | Mild interstitial nephritis | NSF |
| 427 | Sarcoma/ sarcoid | NSF | NSF | Focal histiocytic infiltrate | Gastric bots | Mild periportal infiltrate | NSF | NSF |
| 429 | NSF | NSF | NSF | Multifocal pleural fibrosis | Mesenteric lipoma | NSF | NSF | NSF |
| 431 | Scar, right hock | NSF | NSF | NSF | Gastric bots | Mild periportal infiltrate | Mild interstitial nephritis | NSF |
| Horse | Group | Pre-Infection | 14 DPI, Pre-Tx | 2 Weeks of Tx | 4 Weeks of Tx | 6 Weeks of Tx | 8 Weeks of Tx |
|---|---|---|---|---|---|---|---|
| 417 | 2 | − | + | + | + | + | + |
| 418 | 2 | − | + | + | + | + | + |
| 420 | 2 | − | + | + | + | + | + |
| Horse | Group | Pre-Infection | 14 DPI | 21 DPI | 2 Weeks of Tx at 2.5 mg/kg | 4 Weeks of Tx at 2.5 mg/kg | 6 Weeks of Tx at 2.5 mg/kg | 8 Weeks of Tx at 2.5 mg/kg |
|---|---|---|---|---|---|---|---|---|
| 124 | 3 | − | − | + | + | + | + | + |
| 173 | 3 | − | + | + | + | + | + | + |
| 419 | 3 | − | + | + | + | + | + | + |
Disclaimer/Publisher’s Note: The statements, opinions and data contained in all publications are solely those of the individual author(s) and contributor(s) and not of MDPI and/or the editor(s). MDPI and/or the editor(s) disclaim responsibility for any injury to people or property resulting from any ideas, methods, instructions or products referred to in the content. |
© 2023 by the authors. Licensee MDPI, Basel, Switzerland. This article is an open access article distributed under the terms and conditions of the Creative Commons Attribution (CC BY) license (https://creativecommons.org/licenses/by/4.0/).
Share and Cite
Onzere, C.K.; Hulbert, M.; Sears, K.P.; Williams, L.B.A.; Fry, L.M. Tulathromycin and Diclazuril Lack Efficacy against Theileria haneyi, but Tulathromycin Is Not Associated with Adverse Clinical Effects in Six Treated Adult Horses. Pathogens 2023, 12, 453. https://doi.org/10.3390/pathogens12030453
Onzere CK, Hulbert M, Sears KP, Williams LBA, Fry LM. Tulathromycin and Diclazuril Lack Efficacy against Theileria haneyi, but Tulathromycin Is Not Associated with Adverse Clinical Effects in Six Treated Adult Horses. Pathogens. 2023; 12(3):453. https://doi.org/10.3390/pathogens12030453
Chicago/Turabian StyleOnzere, Cynthia K., Morgan Hulbert, Kelly P. Sears, Laura B. A. Williams, and Lindsay M. Fry. 2023. "Tulathromycin and Diclazuril Lack Efficacy against Theileria haneyi, but Tulathromycin Is Not Associated with Adverse Clinical Effects in Six Treated Adult Horses" Pathogens 12, no. 3: 453. https://doi.org/10.3390/pathogens12030453
APA StyleOnzere, C. K., Hulbert, M., Sears, K. P., Williams, L. B. A., & Fry, L. M. (2023). Tulathromycin and Diclazuril Lack Efficacy against Theileria haneyi, but Tulathromycin Is Not Associated with Adverse Clinical Effects in Six Treated Adult Horses. Pathogens, 12(3), 453. https://doi.org/10.3390/pathogens12030453
